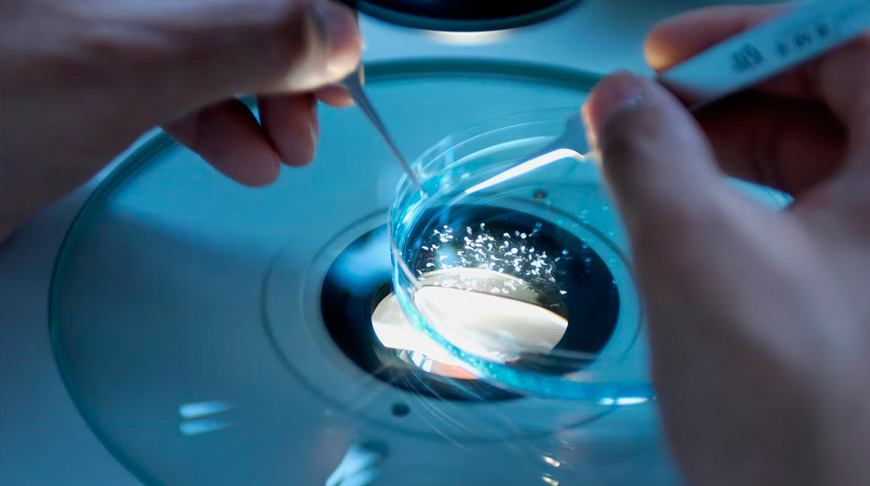

Вместо прививки от коронавируса можно будет выпить стакан кефира. Правда, необычного. И не за раз, а 200 граммов в течение трех дней, после чего через неделю еще столько же. Такую форму защиты от ковида - кефирную вакцину - разрабатывают ученые.
Идея Суворова
О кефирной вакцине директор Института экспериментальной медицины (ИЭМ) профессор Российской академии наук Александр Дмитриев рассказал на презентации, в которой также приняли участие министр здравоохранения Беларуси Дмитрий Пиневич и госсекретарь Союзного государства Дмитрий Мезенцев.
Тема для белорусов не новая. В декабре 2021 года о кефирной вакцине журналистам и ученым рассказывал автор ее идеи Александр Суворов - еще один представитель ИЭМ, доктор медицинских наук.
- Способность пробиоктических вакцин нами исследуется более 20 лет, - сказал Александр Николаевич. - Мы поняли, что микроорганизмы можно генетически модифицировать. Обладая полезными свойствами делать кисломолочные продукты, они могут параллельно производить антигены патогенных микроорганизмов. Так, выпивая необычный кисломолочный продукт, вы защищаете себя от инфекции. Например, пробиотики могут очень эффективно действовать на состояние людей с вирусными заболеваниями, как, например, герпес и грипп.
Когда началась пандемия, ИЭМ переключился на создание вакцины против вируса SARS-CoV-2 на основе кефира.
В чем главное отличие новой вакцины от других? Она защищает человека от инфекции до того, как та проникнет в кровь: антитела против вируса начинают вырабатываться уже на слизистой. Причем возникающие при этом иммуноглобулины класса А более активно нейтрализуют его, чем антитела класса G, которые вырабатываются в крови.
Кефирная вакцина для животных
В Беларуси уже планировали разработку кефирной вакцины. Правда, для животных.
- Академия наук ставила задачу проработать возможность создания кефирной вакцины. Однако ее производством не занимаемся. Если будут определены исполнители и вовлечены те, кто владеет этими технологиями, мы, конечно, подключимся к процессу в качестве соисполнителей, - сказал Дмитрий Борисовец, заведующий отделом вирусных инфекций Института экспериментальной ветеринарии имени С. Н. Вышелесского.
Эксперт обратил внимание на то, что при производстве вакцин для животных важен экономический аспект. Себестоимость дозы не должна превышать цену на животное. Не определились в институте и с тем, как ее использовать в условиях содержания животных на фермах. Заливать лечебный кефир в поилки?

Кстати, сотрудники этого института уже трудятся над вакциной от коронавируса для норок. Это совместный проект с РНПЦ эпидемиологии и микробиологии. Ученые РНПЦ работают с вирусом, нарабатывают вакцинную базу, а институт имени С. Н. Вышелесского изучает влияние препарата на иммунитет животных.
Кружка или ампула?
Профессор Суворов предполагает, что делать такую вакцину можно в виде спреев, которые брызгают в нос или рот. Однако преимущество остается на стороне форм, которые проглатываются, - выпитое легче более точно дозировать. Они эффективнее еще и потому, что большинство рецепторов для борьбы с коронавирусом находится в кишечнике.
Почему люди после прививок болеют коронавирусом? Рассказывает инфекционист
Производиться кефирная вакцина может в виде субстанции на основе молочнокислой бактерии, но расфасованной, например, в ампулы или капсулы. Такое мнение высказала генеральный директор ГНПО "Химический синтез и биотехнологии" - директор Института микробиологии НАН Беларуси Эмилия Коломиец, коллектив которой готов к сотрудничеству с российскими коллегами в рамках проекта производства кефирной вакцины.
Пока только классика
Мы попросили прокомментировать возможность участия в разработке кефирной вакцины директора РНПЦ эпидемиологии и микробиологии Владимира Горбунова, который присутствовал на недавней встрече-презентации. Он отметил, что "предложение российской стороны по созданию кефирной вакцины против коронавируса поступило только 15 марта и сейчас рассматривается узкими специалистами и заинтересованными организациями".

Ранее у РНПЦ эпидемиологии и микробиологии опыта работы с кефирной вакциной не было. Вместе с тем центр - основной разработчик первой белорусской вакцины от коронавируса, которая проходит доклинические испытания. Вирус, специально подготовленный и доведенный до незаразной формы, уже прошел тестирование на живых клетках - в пробирке. Результат положительный: прототип вызывает нужную активацию иммунных клеток. Продолжается тестирование на лабораторных животных.
В двух шагах от программы СГ
Так какие же из белорусских научных или научно-практических центров будут работать вместе с российским учеными над кефирной вакциной? Вопрос мы адресовали Министерству здравоохранения.
- Многие СМИ интересуются, работаем ли над кефирной вакциной, - подчеркнула пресс-секретарь Минздрава Юлия Бородун. - Прошла только презентация российской разработки. Но если президенты Беларуси и России решат ее производство (кефирной вакцины. - прим. ред.) облечь в программу Союзного государства, которое выделит деньги на ее реализацию, тогда российские коллеги поделятся с нами своей разработкой. Скорее всего, мы будем участвовать в экспериментальной части - испытании вакцины.
| Тамара МАРКИНА, газета "7 дней", фото из открытых интернет-источников.
ПЕРЕПЕЧАТКА ДАННОГО МАТЕРИАЛА (ПОЛНОСТЬЮ ИЛИ ЧАСТИЧНО) ИЛИ ИНОЕ ЕГО ИСПОЛЬЗОВАНИЕ ЗАПРЕЩЕНЫ
Читайте также:
Ученые выяснили, что коронавирус заставляет мозг уменьшаться. Буквально
Не перепутайте с ОРИ. Как распознать менингококк и чем он опасен?
Почему микротромбы особенно опасны при COVID-19? Объяснил врач-гематолог
- размещаются материалы рекламно-информационного характера.